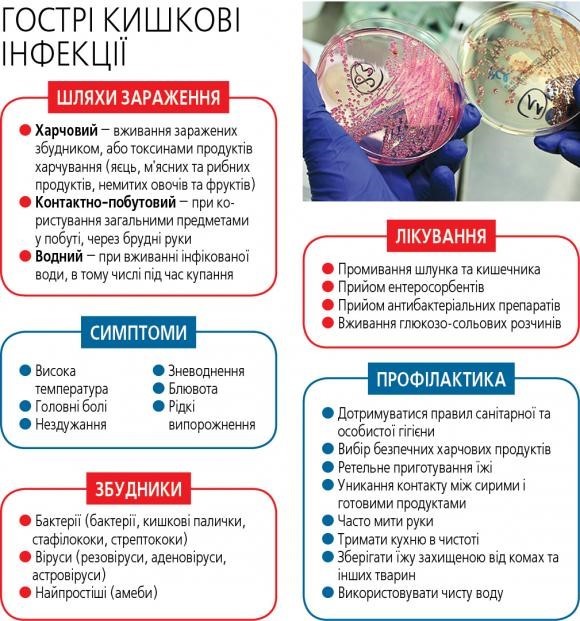
Рекомендації ЦГЗ, які допоможуть надати першу і домедичну допомогу при зневодненні внаслідок кишкової інфекції

Відсутність доступу до чистої води та умов для дотримання гігієни можуть призвести до розвитку кишкових інфекцій, таких як холера, ентеровірусна інфекція, сальмонельоз чи дизентерія. Ці інфекції можуть спричиняти критичне зневоднення організму через втрату рідини внаслідок блювання і рясної діареї, що може розвинутись протягом кількох годин. А це — дуже небезпечно.
Домедична допомога
Передусім необхідно відновити об’єм рідини і мікроелементів організму. Просто пити воду для цього недостатньо. Для відновлення водно-сольового балансу (регідратація) рекомендуйте хворому чи особі, яка за ним доглядає, використати спеціальний розчин. Його можна купити в аптеці без рецепта. Якщо купити не вдалося, можна приготувати розчин із 3,5 чайних ложок цукру і 0,5 столової ложки солі в 1 л води.
Для приготування розчину необхідно використовувати лише безпечну чисту воду: бутильовану, кипʼячену або очищену спеціальними засобами (наприклад, таблетками для очищення).
Потреба з розрахунку за 24 години та за умови вживання рідини через рот із вагою: < 10 кг- 100 мл/кг; 10—20 кг – 1 л для перших 10 кг маси тіла + 50 мл/кг для будь-якого збільшення ваги понад 10 кг; 20—80 кг- 1,5 л + 20 мл/кг на кожен кг для будь-якого збільшення ваги понад 20 кг (максимум 2,4 л на добу).
Важливо пам’ятати, що випоювання краще проводити за допомогою надходження рідини через рот — оральної регідратації, а не через крапельницю (довенну інфузію). Останню використовують тоді, коли неможливо проводити випоювання через рот. Випоювати потрібно правильно — не давати великий об’єм розчинів за один раз, а давати робити ковток кожні п’ять хвилин.
До розчинів для регідратації немовлят на грудному вигодовуванні потрібно обовʼязково годувати грудним молоком, а дітей на штучному вигодовуванні — сумішшю.
Що робити, а що ні, щоб не зашкодити хворому:
• продовжувати давати розчин для регідратації з урахування кожного рідкого випорожнення, поки діарея не мине;
• не давати лікарські засоби, що пригнічують перистальтику кишківника і ліки проти діареї — це може призвести до посилення інтоксикації організму та кишкової непрохідності.
• не давати підсолоджені газовані напої, солодкий сік, чай, оскільки вони можуть посилити діарею.
Медична допомога
Якщо стан хворого не покращується або стає гіршим, рекомендуйте хворому або особі, яка за ним доглядає, викликати «швидку». Якщо такої можливості немає — дізнатися, де розташована найближча лікарня та як швидко можна дістатися туди. У разі деяких кишкових інфекцій зневоднення та інтоксикація можуть відбуватися дуже швидко. Під час очікування швидкої допомоги, дорогою до лікарні потрібно продовжувати напувати хворого розчином для регідратації. Якщо людині складно пити із чашки, розчин можна давати з ложки, зі шприца без голки, зі шприца-піпетки.
Як не заразитися під час догляду за хворим удома:
• ретельно мийте руки з милом після будь-якого контакту із хворим, якщо є доступ до чистої води (змінювали постіль, підгузок, годували, напували, купали, одягали);
• ретельно мийте руки з милом перед вживанням їжі;
• ретельно мийте посуд, який використовував хворий, із використанням побутових мийних засобів;
• протирайте антисептиком поверхні, з якими контактує хворий;
• використовуйте одноразові рукавички, спиртові серветки та антисептики, якщо немає доступу до чистої води.
За перших ознак кишкових інфекцій або у разі зневоднення хворий одразу має звернутися по медичну допомогу.